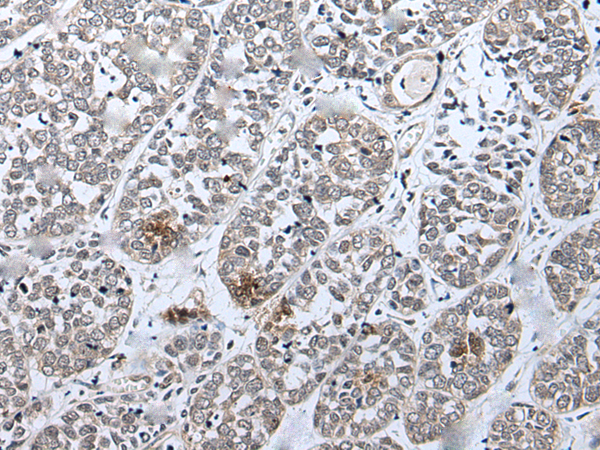
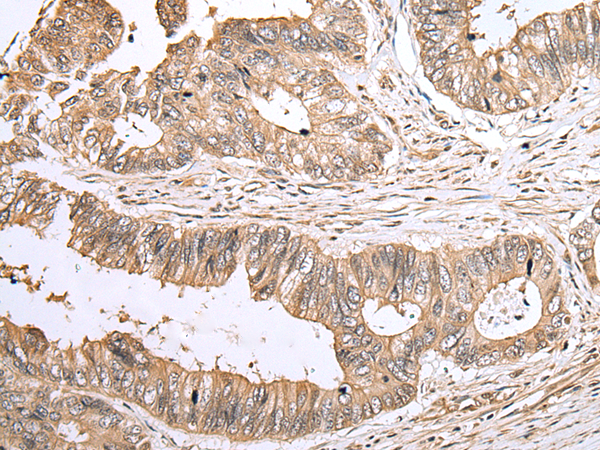
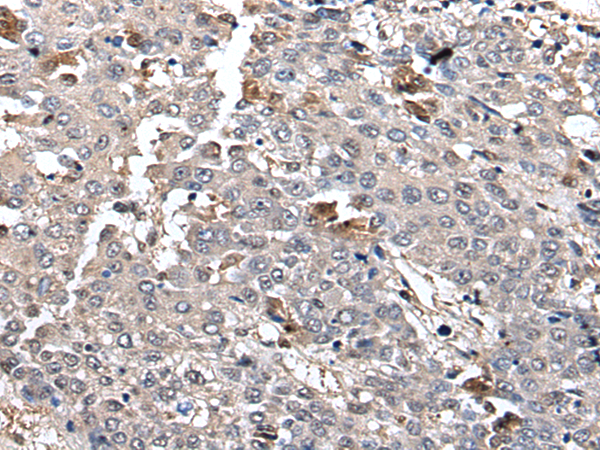
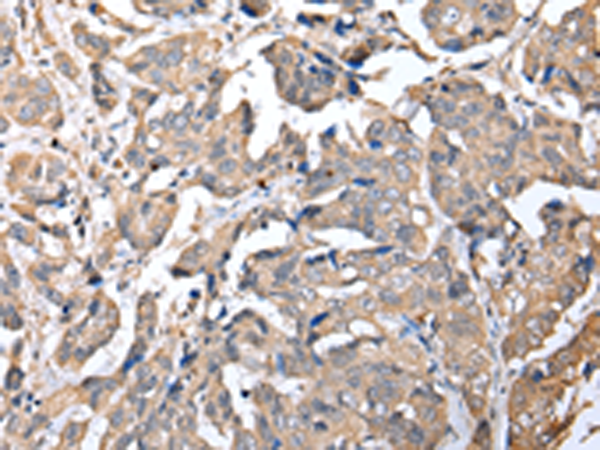

-
分类: 科研抗体货号: P09084别名: SGK196; MDDGA12; MDDGC12应用: WB,IHC反应种属: Human, Mouse, Rat
-
分类: 科研抗体货号: P09066别名: MIR1; CCDC10; FSD1CL; FSD1NL; CSDUFD1应用: IHC反应种属: Human, Mouse
-
分类: 科研抗体货号: P09077别名: gt-V; B4Gal-T5; beta4Gal-T5; beta4GalT-V; BETA4-GALT-IV应用: IHC反应种属: Human, Mouse
-
分类: 科研抗体货号: P09083别名: ZFYVE31应用: IHC反应种属: Human
-
分类: 科研抗体货号: P09065别名: ND; EVR2; FEVR应用: WB,IHC反应种属: Human, Mouse
-
分类: 科研抗体货号: P09076别名: II; CCAT; IGNT; ULG3; GCNT5; GCNT2C; NACGT1; NAGCT1; CTRCT13; bA421M1.1; bA360O19.2应用: IHC反应种属: Human, Mouse
-
分类: 科研抗体货号: P09082别名: ICH-3; ICEREL-III; ICE(rel)III应用: IHC反应种属: Human
-
分类: 科研抗体货号: P09064别名: B1; D1; C18; PTHB1应用: IHC反应种属: Human, Mouse
-
分类: 科研抗体货号: P09075别名: FTP3; HNRPH'; HNRPH2; hnRNPH'应用: WB,IHC反应种属: Human, Mouse, Rat
-
分类: 科研抗体货号: P09081别名:应用: WB,IHC反应种属: Human, Mouse

鄂公网安备42018502007531号
鄂公网安备42018502007531号

